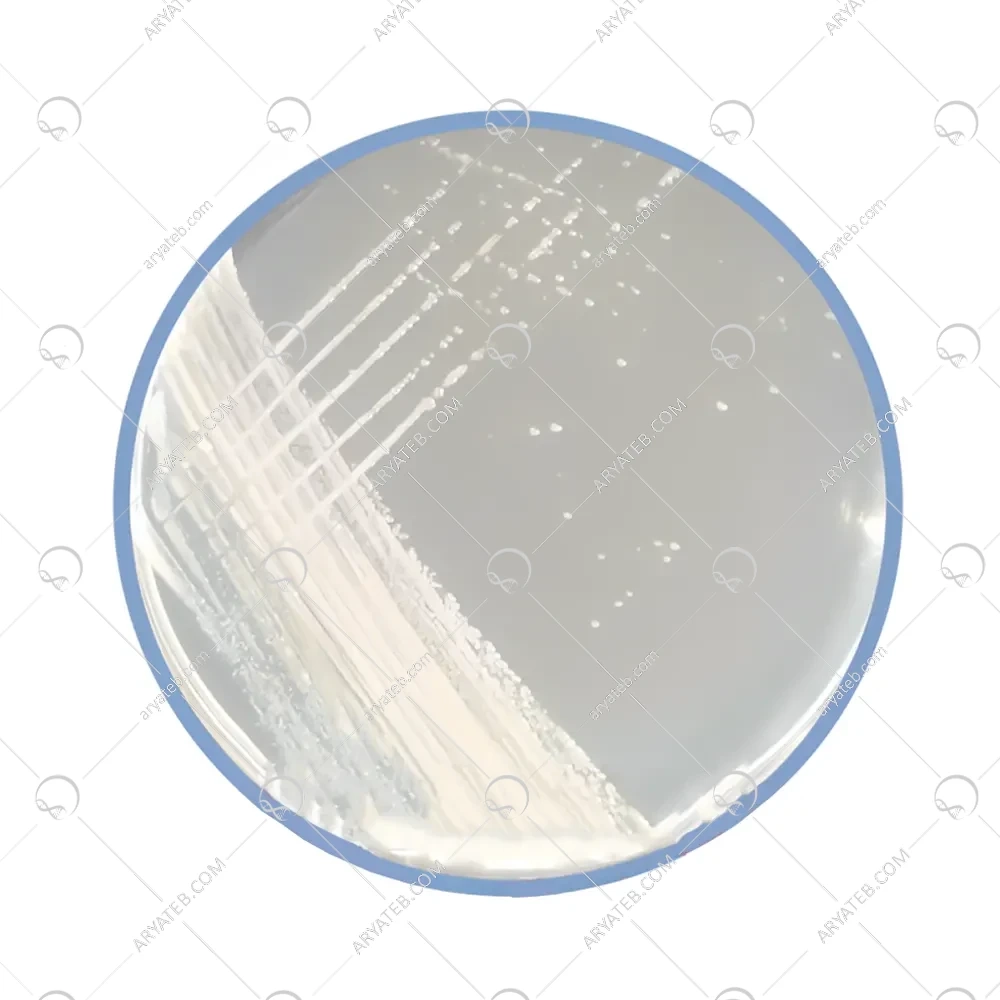

محیط کشت MY40G
- جداسازی و کشت میکروارگانیسم های تحمل کننده اسمزی (Osmotolerant)
محیط کشت MY 40G
محیط کشت MY 40G همانطور که می دانید انواع مختلفی از رسانه های کشت وجود دارد که هر کدام فرمول و ساختار متفاوتی دارند و هر کدام از آنها می توانند برای آزمایش در محیط مورد استفاده قرار گیرند.
محیط کشت MY 40G چیست
وچه کاربردی دارد
مخمرهای اسموفیلیک اغلب عامل فساد غذاهای سرشار از قند مانند مربا ، عسل ، آب میوه های غلیظ ، آب نبات و شکلات نرم هستند. میکروارگانیسم های اسموفیلی را می توان به ارگانیسم هایی که می توانند رشد کنند ، به ویژه در غلظت های بالا و در محیط های غنی از قند ، می گویند. مخمر شایع ترین میکروارگانیسم اسموفیلیک در محیط های غیر یونی با اسمولاریته بالا است ، مانند غذاهایی با قند بالا. محیط کشت MY 40G به معنی عصاره مالت و عصاره مخمر و 40 برای 40٪ گلوکز مورد استفاده در محیط است
ترکیبات محیط کشت MY40G
.jpg)
طرز تهیه محیط کشت MY40G
- 42.7 گرم MY 40G را در 100 میلی لیتر آب حل کنید.
- مخلوط را گرم کنید تا محیط کاملاً حل شود.
- محیط را به مدت 30 دقیقه بخار دهید
- اتوکلاو به دلیل کاهش فعالیت آب ضروری نیست.
شکل ظاهر محیط کشت MY40G
پودر همگن که به رنگ سفید مایل به زرد می باشد.
آدرس ایمیل شما منتشر نخواهد شد. فیلدهای الزامی علامت گذاری شده اند *